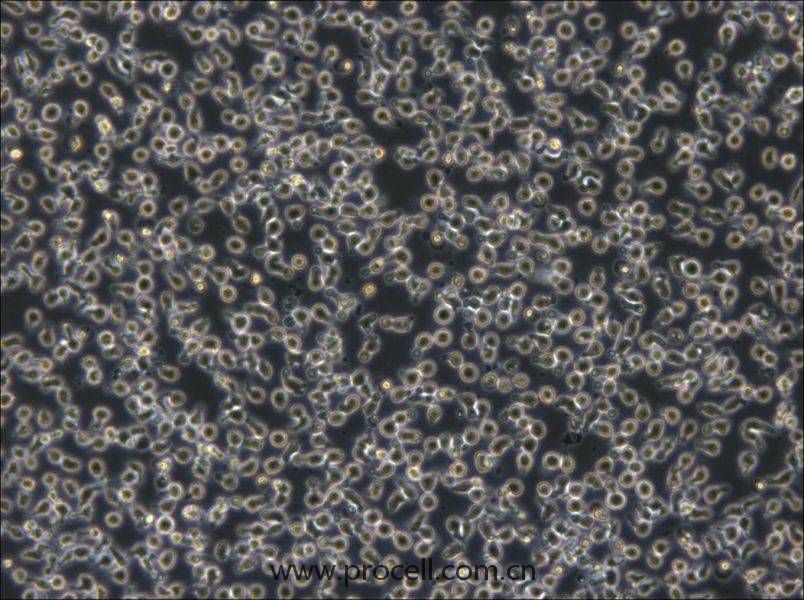
TOLEDO (人彌漫大B細(xì)胞淋巴瘤細(xì)胞) (STR鑒定正確)

產(chǎn)品中心Cell Resources
聯(lián)系我們CONTACT US
400-999-210024小時(shí)服務(wù)熱線(xiàn)
[email protected]銷(xiāo)售郵箱
推薦搭配
套餐1:
細(xì)胞培養(yǎng)最優(yōu)解!
套餐組合價(jià):¥1850¥1950
搭配套餐已成功加入購(gòu)物車(chē)!
產(chǎn)品概述
| 名稱(chēng) | TOLEDO (人彌漫大B細(xì)胞淋巴瘤細(xì)胞) (STR鑒定正確) |
| 別稱(chēng) | Toledo |
| 種屬 | 人類(lèi) |
| 生長(zhǎng)特性 | 懸浮細(xì)胞 |
| 細(xì)胞形態(tài) | 淋巴母細(xì)胞樣 |
| 凍存條件 | 凍存液:55% 基礎(chǔ)培養(yǎng)基+40% FBS+5% DMSO 溫度:液氮 |
| 培養(yǎng)方案A(默認(rèn)) |
培養(yǎng)條件:
氣相:空氣,95%;CO2,5%, 溫度:37℃
|
| 推薦傳代比例 | 1:2-1:4 |
| 推薦換液頻率 | 2-3次/周 |
| 背景描述 | Toledo is a B lymphocyte cell line that was isolated in 1990 from the peripheral blood of a White, adult female patient with diffuse large cell lymphoma, non-Hodgkin's B cell. |
| 年齡(性別) | 女性 |
| 組織來(lái)源 | 外周血 |
| 細(xì)胞類(lèi)型 | 腫瘤細(xì)胞 |
| 腫瘤類(lèi)型 | 淋巴瘤細(xì)胞 |
| 生物安全等級(jí) | BSL-1 |
| 倍增時(shí)間 | 24-30 hours |
| 保藏機(jī)構(gòu) | ATCC; CRL-2631 |
STR鑒定
-
STR位點(diǎn)信息
Amelogenin X CSF1PO 12 D2S1338 19,23 D3S1358 16,18 D5S818 10,12 D7S820 9,10 D8S1179 13 D13S317 11 D16S539 9 D18S51 12 D19S433 15,15.2 D21S11 28,32.2 FGA 19,22 PentaD 11,13 PentaE 10,12 TH01 8,9.3 TPOX 8,11 vWA 16,17 D6S1043 12 D12S391 18,23 D2S441 14 -
STR鑒定圖
-
FAQs
Q:{{item.question}}
A:
產(chǎn)品資料
識(shí)別碼示意圖